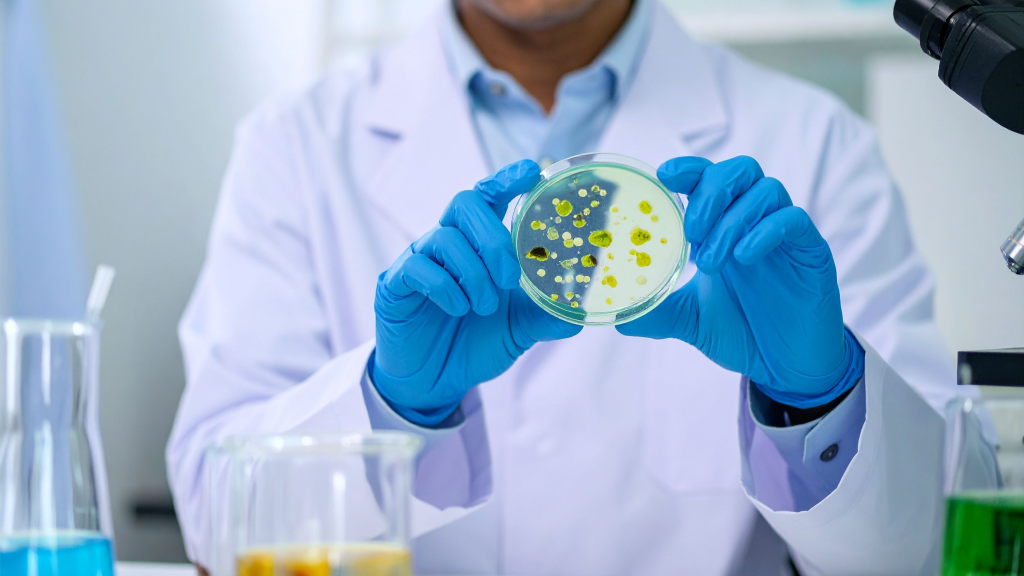

Science & News
At Lo.Li. Pharma International, every step forward tells a story.
We believe that progress gains meaning when it’s shared, that’s why we open the door to the moments, insights, and milestones that build our journey.
From scientific advances to global events, from partnerships to everyday collaboration, this is where our path takes shape.
Science

Preterm birth : why it happens and strategies to prevent it.
WHO estimates that in 2015, 15 million babies are born prematurely. During the pregnancy, every moment is vital for the healthy growth of the baby.

Food Allergens: a public health issue
Allergenic foods have been identified as a food safety hazard and may affect millions of consumers if not properly controlled. According to EAACI (European Academy
PHMB: the safe approach of infection management
Nowadays the increase in resistance of bacteria to antibiotics complicates the treatment of infections. Fortunately, new, highly effective antiseptics are available that lack the drawbacks of
News
How China turned a problem into an opportunity: the CBEC way.
In the early 2000s, the Chinese Government decided to turn into an advantage what had been until that moment an issue for the economic and
Regulatory affairs and its support to companies
The phrase “regulatory compliance” is often accompanied by plenty of groaning, whining, and eye-rolling, particularly from the commercial and marketing department which would like to
The true soul of persuasion
They say ideas are the currency of the 21st Century. Being able to persuade, to change hearts and minds can be the sole greatest skill